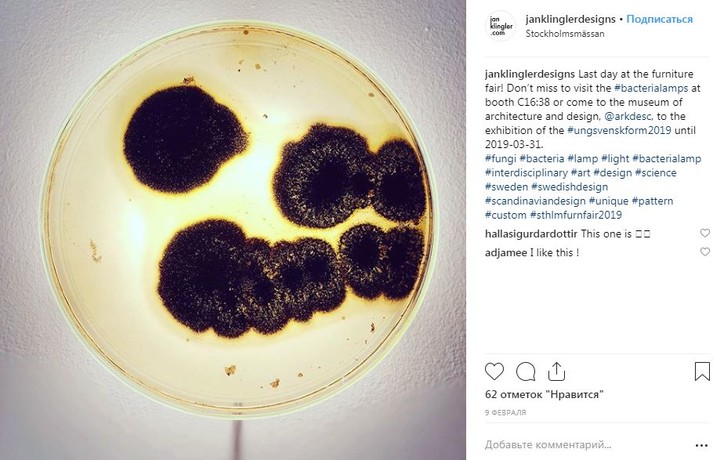

Дизайнер создал серию светильников из наполненных бактериями лабораторных колб

Ян Клинглер сотрудничал с микробиологом в университетской больнице Стокгольма, чтобы создать проект на стыке промышленного дизайна и биологии
Дизайнер Ян Клинглер представил серию светильников Bacteria в емкостях с бактериальными культурами. Об этом сообщает Dezeen.
Клингер собирает бактерии, дрожжи и грибки и оставляет их расти на 24-48 часов. Для размножения бактериям требуется питательная среда — агар или желатин. В начале процесса вещество очень жидкое, но когда оно начинает затвердевать, Клингер добавляет к нему бактерии и позволяет им развиваться.
Дизайнер объясняет, что разные цвета и узоры производят сами микроорганизмы: например, живущая во рту бактерия серратия дает насыщенный оранжево-красный цвет. Как только желаемый эффект достигнут, емкость запечатывают. Это лишает культуры кислорода, поэтому они перестают расти и застывают.
После этого дизайнер подключает колбу к светодиоду, который просвечивает сквозь бактерии. «Бактерия берет на себя художественную работу, как только я ее добавляю. [Сначала] она прозрачна, так что вам придется подождать и посмотреть, во что она сформируется», — говорит Клингер. Светильники выпускают в двух вариантах: в виде настольной лампы и в виде бра.

Коментарі — 0